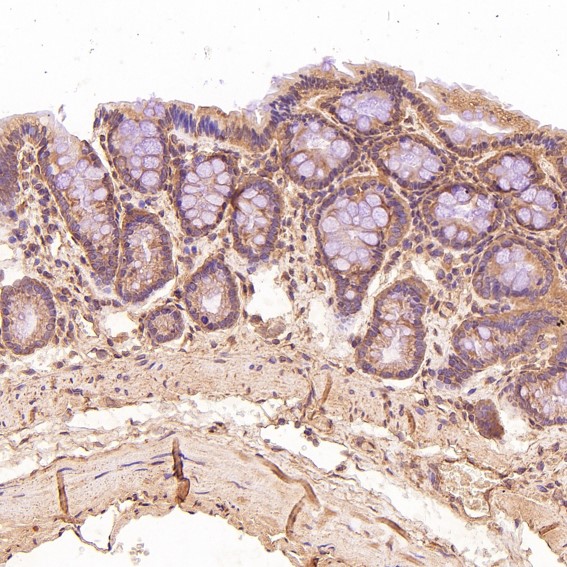

单克隆抗体
CD3D Antibody (CY5982)
UniProt:P04234
Application:WB,IHC,ICC/IF,IP,FC
Reactivity:Human
Source:Rabbit mAb
CD3D Antibody (CY5982)
UniProt:P04234
Application:WB,IHC,ICC/IF,IP,FC
Reactivity:Human
Source:Rabbit mAb
http://www.abways.cn/showproduct.asp?cid=CY5982
FOXP3 Antibody (CY5983)
UniProt:Q9BZS1
Application:WB,IHC
Reactivity:Human
Source:Rabbit mAb
http://www.abways.cn/showproduct.asp?cid=CY5983
KMT6 / EZH2 Antibody (CY5984)
References (1)
UniProt:Q15910
Application:WB,IHC,ICC/IF,FC
Reactivity:Human,Mouse,Rat
Source:Rabbit mAb
KMT6 / EZH2 Antibody (CY5984)
UniProt:Q15910
Application:WB,IHC,ICC/IF,FC
Reactivity:Human,Mouse,Rat
Source:Rabbit mAb
References(1)
http://www.abways.cn/showproduct.asp?cid=CY5984
TSG101 Antibody (CY5985)
References (1)
UniProt:Q99816
Application:WB,IHC,ICC/IF,FC
Reactivity:Human,Mouse,Rat
Source:Rabbit mAb
TSG101 Antibody (CY5985)
UniProt:Q99816
Application:WB,IHC,ICC/IF,FC
Reactivity:Human,Mouse,Rat
Source:Rabbit mAb
References(1)
http://www.abways.cn/showproduct.asp?cid=CY5985
ARID1A Antibody (CY5986)
UniProt:O14497
Application:WB,IHC,ICC/IF
Reactivity:Human,Mouse,Rat
Source:Rabbit mAb
ARID1A Antibody (CY5986)
UniProt:O14497
Application:WB,IHC,ICC/IF
Reactivity:Human,Mouse,Rat
Source:Rabbit mAb
http://www.abways.cn/showproduct.asp?cid=CY5986

销售咨询
销售咨询 一键电话
一键电话